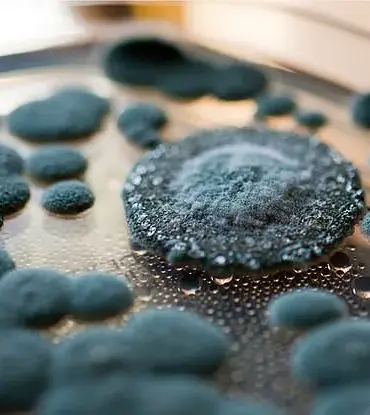
Nationwide Recall of Hostess Ding Dongs Over Mold Concerns as Investigation Reveals Contamination in Specific Batches

JoinedJanuary 29, 2025
Articles256
Antonio Thomas is a seasoned journalist and investigative reporter who has been working at Twincityreport.com for the past decade. Born and raised in Minneapolis, he developed a keen interest in journalism from an early age, often found exploring the city with his trusty notebook and camera, always on the lookout for a good story.
His first big break came when he uncovered a corruption scandal involving a prominent local politician that made national headlines. Since then, Antonio has continued to pursue stories that expose injustice, champion the underdog, and hold power to account. A firm believer in the adage "the truth will set you free," Antonio's passion for journalism is evident in his tireless efforts to bring the facts to light.
When he's not working on a story, Antonio can be found exploring the great outdoors or cooking up a storm in his kitchen. With an unquenchable thirst for knowledge and a never-ending drive to uncover the truth, Antonio Thomas is an indispensable member of the Twincityreport.com team.